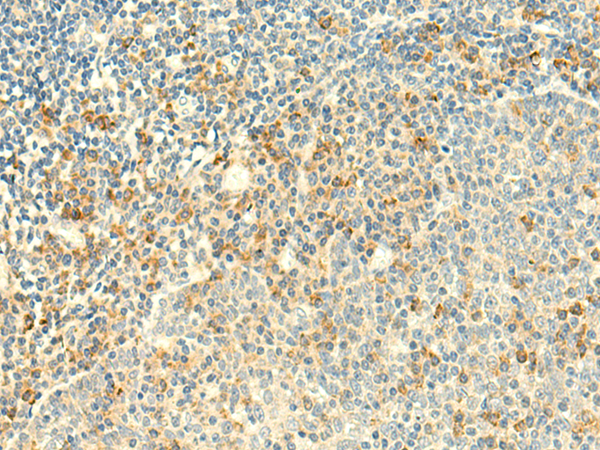

-
分类: 科研抗体货号: P43548别名: C-C motif chemokine 20 (Beta-chemokine exodus-1) (CC chemokine LARC) (Liver and activation-regulated chemokine) (Macrophage inflammatory protein 3 alpha) (MIP-3-alpha) (Small-inducible cytokine A20) [Cleaved into: CCL20(1-67); CCL20(1-64); CCL20(2-70)]应用: IHC反应种属: Human,Mouse
-
分类: 科研抗体货号: P43574别名: Cps25; Saf19; HDPY-30应用: WB,IHC反应种属: Human, Mouse, Rat
-
分类: 科研抗体货号: P43562别名: Collagen alpha-1(XIX) chain (Collagen alpha-1(Y) chain)应用: WB反应种属: Human
-
分类: 科研抗体货号: P43573别名: EIF2; EIF2G; MRXSBRK; eIF-2gA; EIF2gamma应用: WB,IHC反应种属: Human, Rat
-
分类: 科研抗体货号: P43578别名:应用: WB,IHC反应种属: Human, Mouse
-
分类: 科研抗体货号: P43561别名: V-type proton ATPase subunit S1 (V-ATPase subunit S1) (Protein XAP-3) (V-ATPase Ac45 subunit) (V-ATPase S1 accessory protein) (Vacuolar proton pump subunit S1)应用: WB反应种属: Human,Mouse,Rat
-
分类: 科研抗体货号: P43571别名: HSPC107应用: WB,IHC,IF反应种属: Human
-
分类: 科研抗体货号: P43577别名: TF2A2; TFIIA; T18745; TFIIAS; HsT18745; TFIIA-12; TFIIA-gamma应用: WB,IHC反应种属: Human, Mouse, Rat
-
分类: 科研抗体货号: P43587别名: GPR123应用: IHC反应种属: Human, Mouse
-
分类: 科研抗体货号: P43569别名: SPG28; PAPLA1; PA-PLA1应用: WB,IHC,IF反应种属: Human

鄂公网安备42018502007531号
鄂公网安备42018502007531号

